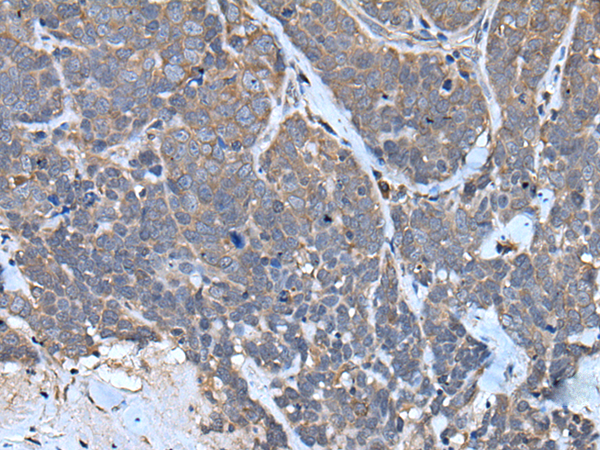

|
Background: |
This gene encodes a protein that is related to chondromodulin-I, which is a cartilage-specific glycoprotein that functions to stimulate chondrocyte growth and to inhibit tube formation of endothelial cells. This protein is also an angiogenesis inhibitor. Genetic variation in this gene is associated with a risk for type 2 diabetes, central obesity and serum levels of systemic immune mediators in a body size-dependent manner. This gene is also a candidate gene for age-related macular degeneration, though a direct link has yet to be demonstrated. |
|
Applications: |
ELISA, WB, IHC |
|
Name of antibody: |
TNMD |
|
Immunogen: |
Synthetic peptide of human TNMD |
|
Full name: |
tenomodulin |
|
Synonyms: |
TEM; CHM1L; BRICD4 |
|
SwissProt: |
Q9H2S6 |
|
ELISA Recommended dilution: |
5000-10000 |
|
IHC positive control: |
Human thyroid cancer |
|
IHC Recommend dilution: |
30-150 |
|
WB Predicted band size: |
37 kDa |
|
WB Positive control: |
Human fetal liver tissue lysate |
|
WB Recommended dilution: |
500-2000 |
購(gòu)物車(chē)
幫助
021-54845833/15800441009
